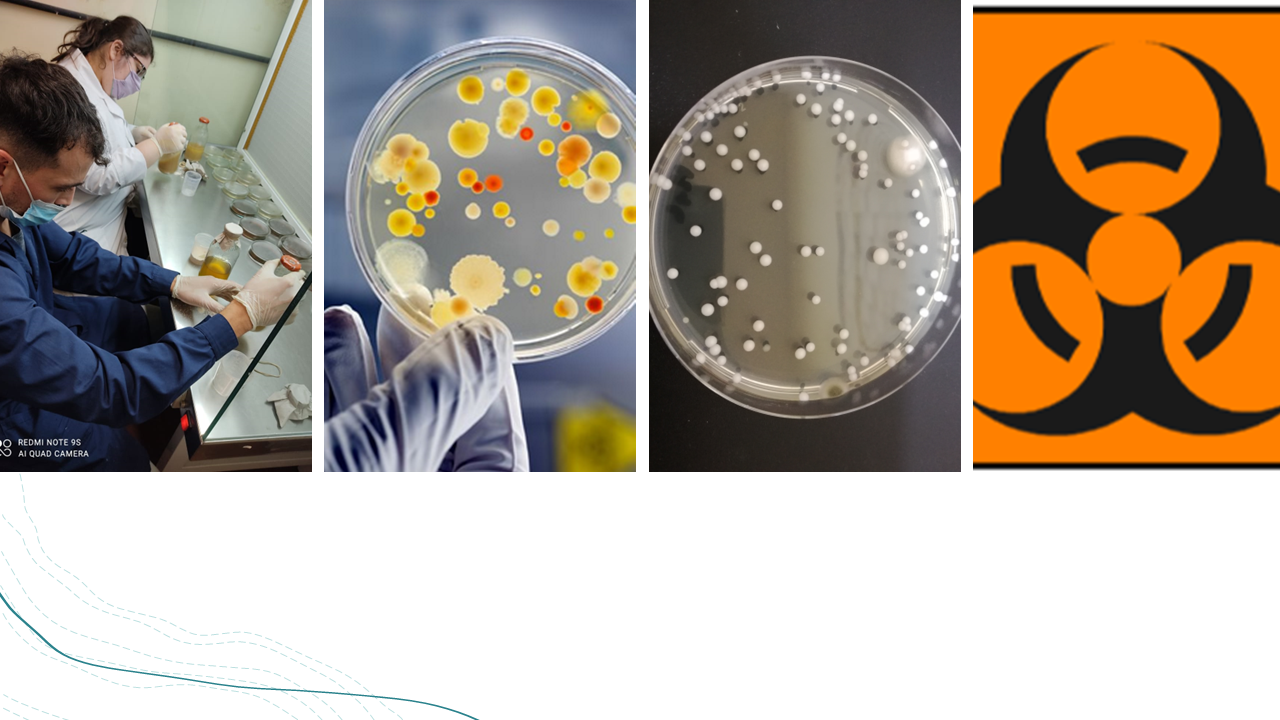

DICTADO de la asignatura de Microbiología General y de los Alimentos de la carrera de Ingeniería Química de la Facultad de Ciencias Exactas, Físicas y Naturales de la UNC.
- Profesor: Bazan, Raquel
- Profesor: CALVIMONTE, Helena
- Profesor: LARROSA, NANCY
- Profesor: LOPEZ, ABEL GERARDO